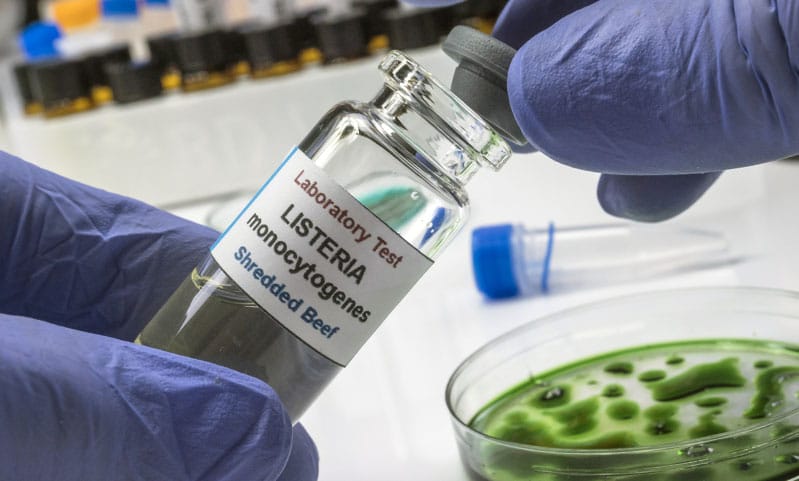
Listeria

We see this word quite a bit, usually in connection with food safety recalls, such as milk products and processed meat.
Listeria is an unusually hardy form of bacteria. It can survive extreme temperature that kill other bacteria, which is the main reason these outbreaks are so common.
Like many bacterial infections, listeriosis doesn’t usually adversely affect healthy people.
However, these infections are often life threatening for pregnant women and their developing fetuses or nursing infants, people older than 65, and people with weakened immune systems.
Legally, injured victims with pre-existing conditions are entitled to maximum compensation, under the eggshell skull rule.
Negligent actors shouldn’t be able to avoid responsibility for their mistakes just because the victim is vulnerable to certain injuries.
Symptoms
Also like most infections, the sooner doctors diagnose it and prescribe antibiotics, the better the outcome.
By the time the Food and Drug Administration (FDA), or another federal agency, pressures companies to recall unsafe food products, thousands of people have already consumed tainted food.
So, it’s important to know the early symptoms of listeriosis, such as:
- Fever,
- Muscle aches,
- Chills,
- Diarrhea, and
- Nausea.
Once the infection spreads to the nervous system, symptoms include neck stiffness, loss of balance, and convulsions.
At this point, listeriosis is much harder to treat.
Mothers should also be aware of the symptoms of listeriosis in their small infants. These infants often can’t tolerate the strong antibiotics needed to treat advanced symptoms. Early symptoms include:
- Fever,
- Irritability,
- Less interest in feeding,
- Trouble breathing, and
- Diarrhea.
Admittedly, many of these symptoms are rather generic. So, if you see them, it’s usually best to err on the side of caution and have your baby tested.
Risk Factors and Complications
Testing is especially a good idea if you, or your baby, has certain risk factors.
We mentioned some of them above. Others include people with HIV, kidney disease, any kind of cancer, liver disease, or take steroids.
People with these listeriosis risk factors are also more likely to develop serious complications, like blood infections and meningitis.
These complications often involve misdiagnosis issues.
Many people don’t connect listeria with meningitis or blood infections, especially if the FDA hasn’t announced a problem.
The FDA doesn’t have the power to recall unsafe products.
It can only pressure companies to voluntarily recall them, or at most, order companies to stop running commercials and otherwise market dangerous products.
Moreover, the FDA depends heavily on user fees from the companies it regulates. So, these officials only issue recall-related orders as a last resort.
When government bureaucrats don’t protect people from bacterial infections or other health and safety hazards, a New York personal injury attorney stands in the gap.
Prevention
As mentioned, listeria is very hard to kill, so cleanliness is usually the easiest and best way to fight all kinds of viral and bacterial infections.
Wash your hands thoroughly with warm, soapy water before and after handling or preparing food.
Then, after cooking, use hot, soapy water to wash the utensils, cutting boards and other food preparation surfaces.
On a related note, before you eat or serve raw vegetables, don’t just rinse them.
Instead, clean them thoroughly with a scrub brush or vegetable brush under plenty of running water.
People with pre-existing conditions should take extra precautions.
Avoid soft cheeses, like feta and queso, as well as cold milk products, like ice cream and frozen yogurt.
Also avoid packaged meats, like deli meats and hot dog wieners. Listeria outbreaks are almost always connected to such foods.
For more information about food safety issues, contact the experienced attorneys at Napoli Shkolnik, .